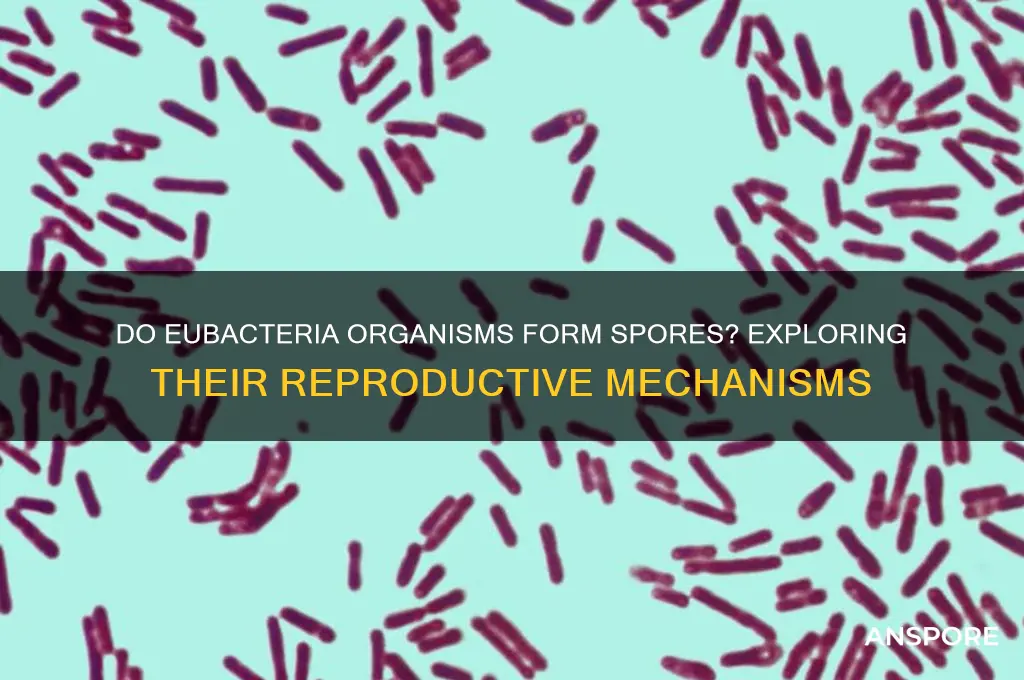
can organisms in eubacteria produce with spores

Eubacteria, a diverse domain of prokaryotic organisms, encompasses a wide range of bacterial species, some of which possess the remarkable ability to produce spores as a survival mechanism. These spores, highly resistant to harsh environmental conditions such as extreme temperatures, desiccation, and chemical exposure, serve as a dormant form of the bacterium, allowing it to persist in unfavorable conditions. While not all eubacteria produce spores, certain groups, such as the Firmicutes (including *Bacillus* and *Clostridium* species), are well-known for their sporulation capabilities. This process involves the formation of a protective endospore within the bacterial cell, which can remain viable for extended periods until conditions become favorable for growth and reproduction. Understanding sporulation in eubacteria is crucial for fields like microbiology, biotechnology, and medicine, as it highlights the adaptability and resilience of these microorganisms in diverse ecosystems.
| Characteristics | Values |
|---|---|
| Kingdom | Eubacteria (also known as Bacteria) |
| Sporulation Ability | Some organisms in Eubacteria can produce spores, while others cannot. |
| Types of Spores | Endospores (e.g., in Bacillus and Clostridium species) |
| Function of Spores | Survival in harsh conditions (e.g., heat, desiccation, chemicals) |
| Location of Spores | Formed within the bacterial cell (endospores) |
| Sporulation Process | Involves asymmetric cell division and spore coat formation |
| Examples of Spore-Forming Bacteria | Bacillus anthracis, Clostridium botulinum, Sporosarcina spp. |
| Non-Spore Forming Bacteria | Escherichia coli, Staphylococcus aureus, Streptococcus spp. |
| Significance | Spores are highly resistant and can remain dormant for years |
| Medical and Industrial Relevance | Used in vaccines, probiotics, and bioremediation |
Explore related products
What You'll Learn

Endospore Formation in Gram-Positive Eubacteria
Endospore formation is a remarkable survival strategy employed by certain Gram-positive eubacteria, notably within the genus *Bacillus* and *Clostridium*. Unlike vegetative cells, which are susceptible to harsh conditions, endospores are highly resistant to extreme temperatures, desiccation, radiation, and chemicals. This resilience allows them to persist in environments that would otherwise be lethal, ensuring the long-term survival of the species. Understanding the process of endospore formation is crucial for fields such as microbiology, biotechnology, and food safety, as these structures can pose challenges in sterilization and contamination control.
The process of endospore formation, or sporulation, involves a series of morphological and biochemical changes within the bacterial cell. It begins with the asymmetric division of the cell, resulting in a smaller forespore and a larger mother cell. The forespore is then engulfed by the mother cell, forming a structure known as the sporulating cell. Within this structure, the forespore undergoes a series of maturation steps, including the synthesis of a thick, multi-layered spore coat and the dehydration of the cytoplasm. This coat, composed of proteins and peptidoglycan, is a key factor in the endospore's resistance to environmental stressors. The mother cell, having completed its role, eventually lyses, releasing the mature endospore into the environment.
From a practical standpoint, the ability of Gram-positive eubacteria to form endospores has significant implications for food preservation and medical sterilization. For instance, *Clostridium botulinum* endospores can survive in improperly canned foods, leading to botulism if ingested. To mitigate this risk, food processing techniques such as autoclaving (121°C for 15–30 minutes) are employed to destroy endospores. Similarly, in medical settings, surgical instruments are sterilized using high-pressure steam to ensure the elimination of these resilient structures. Understanding the conditions required to inactivate endospores is essential for developing effective sterilization protocols.
Comparatively, endospore formation in Gram-positive eubacteria stands in contrast to the reproductive strategies of other microorganisms. While fungi produce spores as part of their life cycle, bacterial endospores are not reproductive structures but rather dormant, protective forms. This distinction highlights the unique evolutionary adaptation of Gram-positive bacteria to survive in adverse conditions. Furthermore, the study of endospore formation has inspired biotechnological applications, such as the use of *Bacillus thuringiensis* endospores as bioinsecticides, leveraging their durability and toxicity to target pests.
In conclusion, endospore formation in Gram-positive eubacteria is a fascinating and functionally critical process that underscores the adaptability of these microorganisms. By producing endospores, bacteria like *Bacillus* and *Clostridium* ensure their survival in environments that would otherwise be inhospitable. This mechanism has far-reaching implications, from food safety and medical sterilization to biotechnology, making it a subject of ongoing research and practical importance. Understanding the intricacies of endospore formation not only advances scientific knowledge but also informs strategies to control and utilize these resilient bacterial forms effectively.
Can Apple TV Spread Spores? Unveiling the Truth Behind the Myth
You may want to see also

Exospore Production in Certain Eubacterial Species
Eubacteria, a vast domain of prokaryotic organisms, encompasses a remarkable diversity of survival strategies. Among these, exospore production stands out as a unique mechanism employed by certain species to endure harsh environmental conditions. Unlike endospores, which form within the bacterial cell, exospores develop externally, often attached to the cell surface. This distinction is crucial, as it influences the spore's structure, function, and ecological role. For instance, *Streptomyces*, a genus of Gram-positive bacteria, is renowned for producing exospores that contribute to its survival in soil environments. These spores are not only resistant to desiccation and temperature extremes but also play a pivotal role in the dispersal of the species.
Analyzing the process of exospore formation reveals a complex interplay of genetic and environmental factors. In *Streptomyces*, sporulation is triggered by nutrient depletion, initiating a cascade of regulatory events. The bacterium undergoes morphological changes, including the formation of aerial hyphae, which eventually fragment into spore-like structures. These exospores are encased in a protective coat composed of proteins and lipids, enhancing their resilience. Interestingly, the composition of this coat can vary depending on the environmental conditions, allowing the spores to adapt to specific challenges. For example, exposure to UV radiation may induce the production of thicker coats, providing additional protection against DNA damage.
From a practical standpoint, understanding exospore production has significant implications for biotechnology and agriculture. *Streptomyces* species are prolific producers of bioactive compounds, including antibiotics, and their exospores serve as a means of preserving and disseminating these valuable molecules. In agricultural settings, exospore-forming bacteria can be harnessed for soil remediation and plant growth promotion. For instance, inoculating crops with *Streptomyces* spores has been shown to enhance nutrient uptake and disease resistance. However, it is essential to consider the potential risks, such as the transfer of antibiotic resistance genes, and implement controlled applications to maximize benefits while minimizing adverse effects.
Comparatively, exospore production in eubacteria contrasts with other spore-forming mechanisms, such as those seen in fungi or certain protists. While fungal spores are typically haploid and result from meiosis, bacterial exospores are formed through asexual processes and retain the genetic material of the parent cell. This difference underscores the evolutionary divergence in survival strategies across kingdoms. Moreover, the external nature of exospores facilitates rapid dispersal, a feature particularly advantageous in dynamic environments like soil ecosystems. In contrast, endospores, such as those produced by *Bacillus* species, prioritize long-term survival in a dormant state, often remaining viable for decades.
In conclusion, exospore production in certain eubacterial species represents a specialized adaptation with profound ecological and applied significance. By examining the mechanisms, environmental triggers, and practical applications of this process, we gain insights into the resilience and versatility of eubacteria. Whether in the context of antibiotic discovery, agricultural innovation, or environmental conservation, exospores offer a fascinating lens through which to explore the microbial world. As research continues to unravel the intricacies of exospore formation, its potential to address global challenges in health, agriculture, and sustainability becomes increasingly evident.
Applying Milky Spore Before Rain: Timing Tips for Effective Lawn Treatment
You may want to see also

Environmental Triggers for Spore Development
Spore formation in eubacteria, particularly within the Firmicutes phylum, is a survival strategy triggered by environmental stressors. When nutrients deplete below a critical threshold—typically less than 0.1% glucose in the medium—cells initiate sporulation. This metabolic shift prioritizes long-term survival over immediate growth, ensuring the organism’s persistence in harsh conditions. For example, *Bacillus subtilis* responds to starvation by activating the Spo0A protein, a master regulator that orchestrates the sporulation cascade. This mechanism underscores how nutrient scarcity acts as a precise environmental cue for spore development.
Temperature fluctuations also play a pivotal role in triggering sporulation. In *Clostridium botulinum*, exposure to temperatures above 37°C (98.6°F) accelerates spore formation, a response likely evolved to cope with sudden heat stress in its natural habitat. Conversely, some psychrophilic bacteria, like *Bacillus psychrophilus*, sporulate in response to cold shock, demonstrating that temperature extremes—both high and low—can act as potent environmental triggers. These responses highlight the adaptability of spore-forming bacteria to diverse thermal niches.
Desiccation is another critical factor driving spore development. In arid environments, water availability can drop below 10% relative humidity, prompting bacteria like *Bacillus megaterium* to initiate sporulation. The process involves synthesizing a protective spore coat and dehydrating the cell, reducing metabolic activity to near-zero levels. This adaptation allows spores to withstand decades of dryness, only resuming growth upon rehydration. Practical applications of this knowledge include using desiccation-induced spores in biotechnology, such as in the production of drought-resistant probiotics.
Oxygen levels further modulate spore formation, particularly in facultative anaerobes like *Desulfotomaculum*. When oxygen concentrations rise above 5% in their environment, these bacteria sporulate to evade oxidative stress. This response is mediated by the sigma factor SigB, which activates genes involved in spore coat synthesis. Understanding this oxygen-driven mechanism is crucial for industries like wastewater treatment, where managing spore formation can prevent biofilm-related clogs in anaerobic digesters.
Finally, pH shifts serve as a less-explored but significant trigger for spore development. Acidic conditions, such as a drop to pH 4.5, induce sporulation in *Geobacillus stearothermophilus*, a thermophile found in hot springs. This response is thought to protect the organism from proton-induced damage to cellular machinery. Conversely, alkaline stress triggers sporulation in *Alkalibacillus*, showcasing how bacteria tailor their spore-forming strategies to specific pH challenges. Monitoring pH in industrial fermentations can thus mitigate unwanted sporulation, ensuring consistent product yields.
By recognizing these environmental triggers—nutrient depletion, temperature extremes, desiccation, oxygen exposure, and pH shifts—researchers and practitioners can manipulate conditions to control spore development in eubacteria. Whether optimizing biotechnological processes or combating bacterial persistence in clinical settings, understanding these cues provides actionable insights into managing microbial behavior.
Ultimate Sterilization: Processes That Annihilate All Microbial Life, Including Spores
You may want to see also
Explore related products

Survival Mechanisms of Eubacterial Spores
Eubacterial spores are nature's ultimate survival capsules, engineered to endure conditions that would annihilate most life forms. These dormant structures, produced by certain bacteria like *Bacillus* and *Clostridium*, can withstand extreme temperatures, desiccation, radiation, and chemicals. Their resilience lies in a multi-layered protective shell, including a thick spore coat and a cortex rich in peptidoglycan, which shields the genetic material and core enzymes. This design allows spores to persist in soil, water, and even outer space for centuries, waiting for favorable conditions to reactivate.
Consider the spore's metabolic shutdown as a strategic hibernation. During sporulation, the bacterium diverts resources to fortify the spore, reducing water content and synthesizing dipicolinic acid (DPA), a molecule that binds calcium ions to stabilize DNA and proteins. This process is so effective that spores can survive autoclaving at 121°C for 15 minutes, a standard sterilization method. For comparison, most vegetative bacteria are destroyed within seconds at this temperature. Understanding this mechanism is crucial for industries like food preservation and healthcare, where spore-forming pathogens like *Clostridium botulinum* pose significant risks.
To neutralize eubacterial spores, specific strategies are required. Chemical agents like hydrogen peroxide or chlorine compounds disrupt the spore coat, while heat treatment must exceed 100°C to penetrate the protective layers. In laboratory settings, researchers use a process called tyndallization, involving three successive heating cycles at 100°C over 24 hours, to ensure complete spore destruction. For home canning, the USDA recommends processing low-acid foods at 240°F (116°C) for 20–100 minutes, depending on the recipe, to eliminate spores that cause botulism.
Comparing eubacterial spores to other microbial survival strategies highlights their uniqueness. While fungi produce spores for dispersal, eubacterial spores are primarily about endurance. Unlike cysts formed by parasites like *Giardia*, which are less resistant, bacterial spores are virtually indestructible in the absence of specific triggers. This distinction underscores the evolutionary advantage of sporulation as a survival mechanism. For instance, *Bacillus anthracis* spores can remain viable in soil for decades, causing anthrax outbreaks when ingested by livestock or humans.
In practical terms, managing spore-forming bacteria requires vigilance and targeted interventions. In healthcare, proper sterilization of medical equipment is non-negotiable, as spores can survive standard cleaning protocols. In agriculture, crop rotation and soil treatment can reduce spore populations, minimizing disease risk. For individuals, understanding spore resilience emphasizes the importance of thorough cooking and proper food storage. While spores are a testament to life's tenacity, their survival mechanisms also remind us of the need for precise, science-backed strategies to control them.
Can Fungi Reproduce Without Spores? Exploring Alternative Reproduction Methods
You may want to see also

Role of Spores in Eubacterial Reproduction
Spores are a critical survival mechanism for certain eubacteria, enabling them to endure harsh environmental conditions that would otherwise be lethal. Unlike vegetative cells, which are metabolically active and vulnerable to stressors like heat, desiccation, and chemicals, spores are dormant, highly resistant structures. This resistance is achieved through a thick, multilayered cell wall rich in peptidoglycan and additional protective compounds like dipicolinic acid. For example, *Bacillus anthracis*, the causative agent of anthrax, forms spores that can survive in soil for decades, waiting for favorable conditions to reactivate.
The process of spore formation, or sporulation, is a complex, energy-intensive response triggered by nutrient deprivation. In *Bacillus subtilis*, a model organism for studying sporulation, the process begins with an asymmetrically dividing cell, forming a smaller forespore and a larger mother cell. The mother cell engulfs the forespore, which then develops the protective layers necessary for survival. This mechanism ensures that even if the vegetative population perishes, the species can persist through its spores.
From a practical standpoint, understanding spore formation is essential for industries like food preservation and healthcare. Spores of *Clostridium botulinum*, for instance, can survive boiling temperatures (100°C) for several minutes, making them a significant concern in canned foods. To eliminate such spores, food manufacturers use high-pressure processing (HPP) or autoclaving at 121°C for at least 15 minutes. Similarly, in medical settings, spore-forming pathogens like *Clostridioides difficile* require stringent disinfection protocols, often involving chlorine-based cleaners or UV light, to prevent nosocomial infections.
Comparatively, not all eubacteria produce spores, and those that do belong to specific genera such as *Bacillus*, *Clostridium*, and *Sporosarcina*. This distinction highlights the evolutionary advantage of sporulation in environments prone to extreme fluctuations. For instance, soil-dwelling bacteria benefit from sporulation to survive seasonal droughts, while gut microbiota typically do not form spores due to the relatively stable conditions of the digestive tract. This diversity underscores the adaptability of eubacteria to their ecological niches.
In conclusion, spores play a pivotal role in eubacterial reproduction by ensuring long-term survival in adverse conditions. Their formation is a sophisticated, energy-demanding process that varies across species, reflecting their specific environmental challenges. For industries and researchers, understanding spore biology is crucial for developing effective strategies to control or harness these resilient structures, whether in food safety, medicine, or biotechnology.
Mold Spores in Vents: Uncovering Their Link to Inflammation Risks
You may want to see also
Frequently asked questions
No, not all organisms in Eubacteria can produce spores. Only certain groups, such as Bacillus and Clostridium, have the ability to form spores as a survival mechanism.
Spore production in Eubacteria serves as a survival strategy, allowing the organism to withstand harsh environmental conditions such as heat, desiccation, and chemicals.
No, Eubacterial spores are not reproductive structures. They are dormant, highly resistant cells that can germinate into active bacteria when conditions become favorable.
Eubacteria form spores through a process called sporulation, where a thick, protective layer is created around the bacterial DNA, enabling it to survive extreme conditions.
Eubacterial spores are highly resilient and can be found in a wide range of environments, including soil, water, and even extreme habitats like hot springs and deep-sea vents.

























